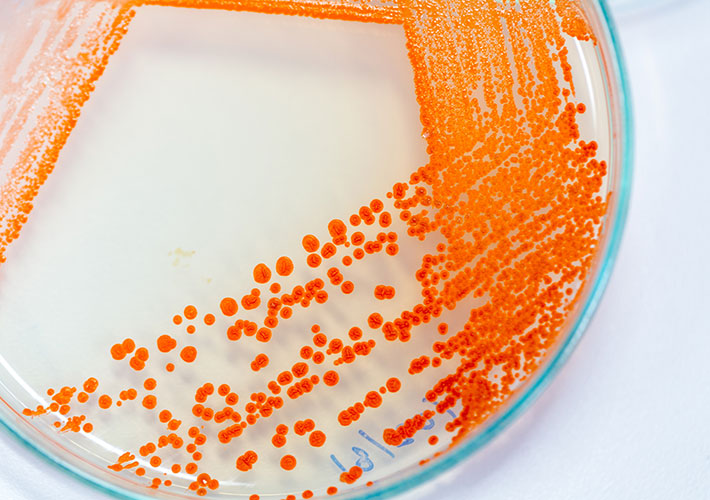
News image

Nov 26, 2018
A new ASTM International standard will help minimize microbial contamination of culture plate media and sampling devices used in indoor air quality investigations. The standard describes how to sample and transport culturable airborne fungi and bacteria samples using agar plates.
"This standard is valuable when species-level identification or quantity of fungi and bacteria are important factors for indoor air quality investigations because proper handling of agar plates and sampling equipment is crucial to minimizing contamination,” says ASTM International member Dr. John Neville, the director at Mycologic Consulting.
Building inspectors, industrial hygienists, indoor air quality specialists, and health, safety, and environmental professionals will find the new standard useful, he says. ASTM International’s air quality committee (D22) developed the standard, soon to be published as D8068.
Neville notes that the subcommittee that developed the new standard is working on more standards that include microbiology analysis of culturable fungi collected with swabs, bulk samples, and air inertial impactors. All interested parties, particularly specialists in microbiology, consulting, and remediation contracting, are welcome to participate in the development of these standards.
To purchase standards, contact ASTM International customer relations (tel +1.877.909.ASTM).
January / February 2019